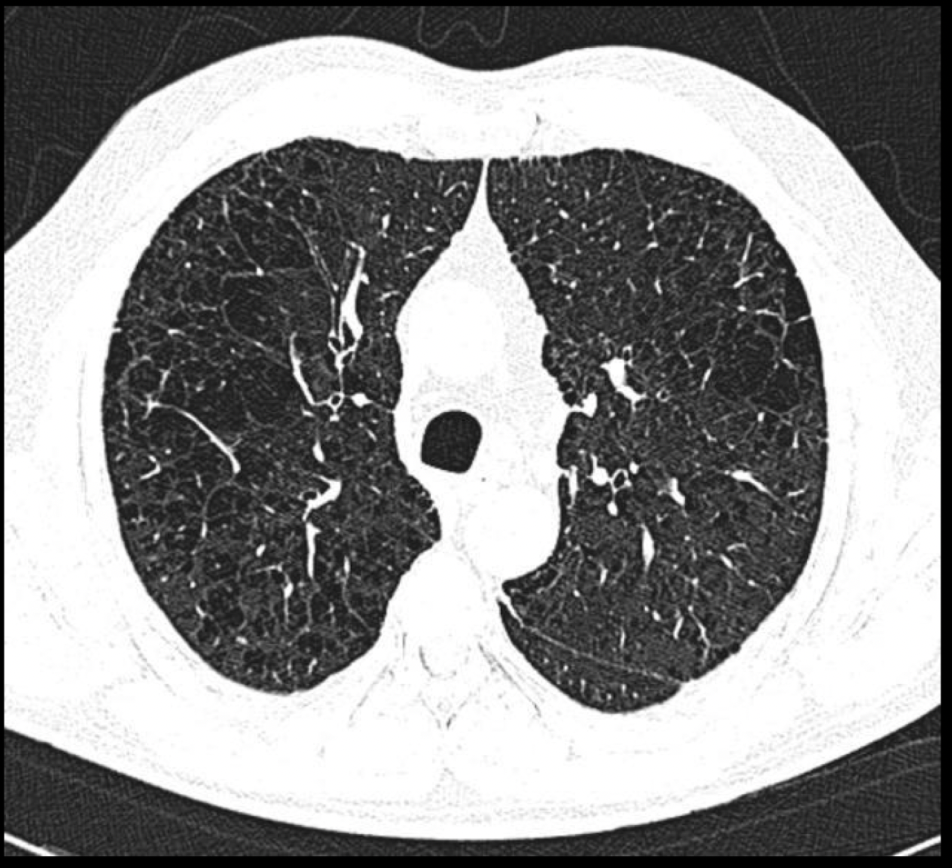

¿Cuáles son los dos px característicos de EPOC?
- Enfisema pulmonar (soplador rosado)
- Bronquitis crónica (abotargado azul)
¿A qué costilla debe llegar el diafragma en insuflasión?
10-11
Carácterísticas de la RX en enfisema
- Aplanamiento del diafragma
- Disminución de marcas broncovasculares periféricas.
- Hiperlucidez pulmonar
- Bullas
- Corazón en gota
¿De qué nos habla un aplanamiento de las costillas y aumento de los espacios intercostales?

ENFISEMA
Esta lesión es característica de enfisema pulmonar, ¿cuál es y por qué piensas que es esta?

Bullas, paredes delgadas e irregulares
Esta aplanamiento del diafragma con sobreposición del pulmón con el colon nos habla de que enfermedad

Enfisema pulmonar
¿Qué nos permite la TC en EPOC?
- Distinguir distribución (paraseptal, centrolobulillar y panlobulillar)
- Engrosamiento bronquial
- Atrapamiento del aire
¿Patrones de distribución que tiene el EPOC?


Patrón que podemos ver
Centrolobulillar
Patrón que podemos ver

Paraseptal
Patrón que podemos ver

Panlobulillar
Patrón visible en rx y TC en bronquitis crónica
- Patrón intersticial grueso
- Imágenes en riel
- Manguitos peribronquiales
¿Qué patrón es, qué signo es y de qué enfermedad es?

- Bronquiectasia
- Rieles de tren
- Bronquitis crónica
¿Qué signo es y que enfermedad lo tiene?

Manguito peribronquial
Bronquitis crónica
¿Qué signos encuentras que te indican de una bronquitis crónica?




